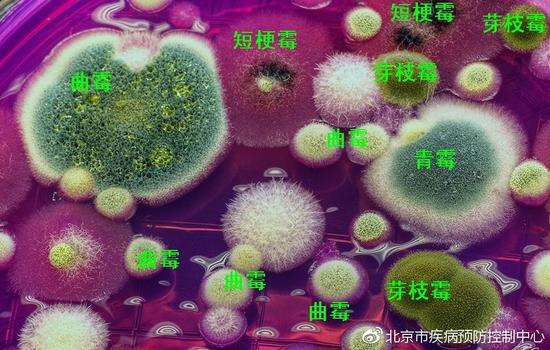
家禽养殖中如何避免霉菌毒素中毒,家禽饲料中霉菌毒素最高标准
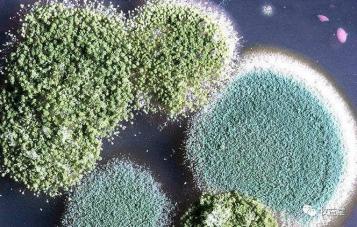
家禽养殖中如何避免霉菌毒素中毒,家禽饲料中霉菌毒素最高标准

家禽养殖中的霉菌毒素
在家禽养殖生产中,人们对霉菌危害的认知多限于已经形成的明显病症。例如:禽的曲霉菌病、白色念珠菌病等;另一方面,人们对霉菌滋生和霉菌毒素传播的条件的认知,多限于是高温高湿地区或高温高湿季节。实际上,霉菌及毒素的危害远比人们通常的认知要严重的多,霉菌的扩散与污染也远比人们通常的认知要广泛的多。有人说,我们这个地区从未发生过一例霉菌病或是霉菌毒素中毒症;那只是说没有出现明显的典型症候或者是出现了但被误诊为其他疾病了亦或是继发了其他较为典型的疾病。不同霉菌毒素对家禽造成的危害有所区别,在已经知道的霉菌毒素中对家禽影响及毒害作用较大的有麦角毒素、单端孢霉毒素、腐马毒素、玉米赤霉烯酮、黄曲霉毒素、赭曲霉毒素等。
本文从认识霉菌及毒素、霉菌毒素来源、对家禽的危害、霉菌毒素临床症状、解剖症状、本病难以诊断和预防措施等方面进行阐述。
1.认识霉菌及毒素
霉菌是丝状真菌的俗称,意即"发霉的真菌",它们往往能形成分枝繁茂的菌丝体。在潮湿温暖的地方,很多物品上长出一些。肉眼可见的绒毛状、絮状或蛛网状的菌落,那就是霉菌。菌丝体常呈白色、褐色、灰色,或呈鲜艳的颜色(菌落为白色毛状的是毛霉,绿色的为青霉,黄色的为黄曲霉),有的可产生色素使基质着色。霉菌有的使食品转变为有毒物质,有的可能在食品中产生毒素,即霉菌毒素。

2.霉菌毒素的来源
2.1饲料原料端
任何生长中的农作物,包括饲草和谷物等,都容易受到霉菌的污染同时产下霉菌毒素。霉菌在随农作物由田间向饲料加工厂再向饲料槽的转换过程中,可能不会存活下来,但是霉菌毒素却完整地保留了下来。饲料原料看上去颜色外观都不错,常规指标检测分析结果也不错。但往往就是这些不错的原料很可能早就已经成为霉菌毒素的避风港了。

收获后的农作物,如果在贮存、运输、加工、保藏的过程中外环境满足霉菌的生长需求,霉菌是会继续生长产毒的。霉菌毒素会一直积累叠加,最终危害动物机体而不自知。曲霉菌(Aspergillu)和青霉菌(Penicillium)是作物收获后导致作物霉变危害最大的霉菌。据报道,全世界每年约有1/4的谷物和饲料原料被霉菌毒素污染,还有统计说,每年被霉菌毒素污染的饲料达到了90%。
有研究表明,霉菌毒素的危害是全年性的,烟曲霉菌毒素、黄曲霉菌毒素适合于温热气候生长,而赭曲霉毒素、玉米赤霉烯酮、呕吐毒素、T-2毒素等常见于寒冷高湿的气候地区。
2.2养殖场端
部分养殖场饮水器漏水或者有水洒进料槽,导致料槽内经常湿料,如果没净槽新料覆盖,下面湿料容易发酸,进而霉变(夏季高温高湿2小时就能发酸,4小时就能滋生霉菌毒素);部分散养鸡、鸭等垫料发霉;舍内及用具不卫生垫料更换不勤,空气及地面污浊,造成舍内霉菌孢子漂浮在舍内污染鸡群。

养殖场料库饲料管理措施不到位,漏雨、返潮等现象或"先进先出"原则执行不到位等导致饲料发霉变质。
3.霉菌毒素的危害
a对饲料及原料质量的破坏,饲料及原料的营养大打折扣,饲养管理不良情况下的低标准量中毒。如:高温、通风差、拥挤、粪便清理不及时、免疫反应过强、营养失衡、疾病等会导致畜禽对霉菌毒素的抵抗力下降。由于霉菌毒素是小分子化合物,机体对其不产生抗体。
b对畜禽消化道黏膜的强腐蚀性,会形成鸭雏口腔溃疡,食道炎,鸡和其他动物的肠粘膜脱落、坏死,从而影响机体对营养物质的消化、吸收。

c对肝脏、肾脏的破坏,造成肝细胞坏死,充血后期形成"橡皮肝",肝脏有储备糖原的功能,糖原减少,发生低血糖症,往往饮葡萄糖无效;还会干扰肝脏卵黄前体的合成和运输,进而造成产蛋率下降和产小蛋增多;肾脏的损伤,可致肾肿、痛风、软骨组织发育不良,畜禽腿病发病率升高。

d对血管壁的损伤,使畜禽血压升高,加重心脏负担和脏器组织渗透压升高,诱发腹水症。
e对免疫器官的损伤。对肠道免疫系统的破坏外,尤其会造成鸡胸腺、法氏囊的萎缩,T淋巴细胞和白细胞减少,白蛋白和球蛋白含量降低,抗体效价下降,血清抗体浓度降低,引起免疫抑制而使各种病毒病多发。
f种鸡采食了被黄曲霉毒素污染的日粮所产后代雏鸡对疾病的易感性增加免疫机能差。据测定,这种鸡雏在进行新城疫传支常规免疫后其血清抗体滴度显著低于正常鸡水平,而侵入种蛋中的霉菌毒素会导致鸡鸭等禽类孵化死胎率升高,后代幼雏肌胃先天性损伤,促使肠道病早发,并出现生长障碍,此种情况极易与鸡传贫、呼肠孤感染混淆。
4.霉菌毒素临床症状
蛋鸡方面:采食量下降,产蛋率下降或不升,鸡群吐水,眼睛呈"双眼皮"样。粪便内有不消化的饲料(呈灰褐色或黄绿色),最常见的是拉黑焦油样或黑青泥样粪便,严重鸡群出现零星死亡,产无光泽的不规则暗斑蛋。
肉鸡方面:采食量下降、不增,甚至一直持续,体重增长缓慢,粪便多呈黑焦油样和酱黄色,内有大量没有消化的饲料,部分粪便呈黄色;严重病例,粪便中夹杂有大量脱落的肠黏膜,部分粪便呈条状带有黏性感。
蛋鸡和肉鸡同时伴有摇头、歪脖、头颈不能随意屈曲、共济失调和两腿麻痹的神经症状,还有呼吸困难或张口喘气的呼吸道症状。
5.解剖症状
蛋鸡方面:①部分念珠菌感染的鸡群,鸡只食管内、嗉囊内有大量灰白色麸皮样伪膜,眼睛出现"云雾状"变化。②肌胃角质层有溃烂,腺胃肿胀,腺胃乳头水肿,甚至乳头消失,部分腺胃角质层萎缩明显,易剥离,严重病例腺胃乳头分泌大量黑褐色液体,使胃内存在大量的黑褐色液体。③出现程度不一的肠系膜发黑,肠管浆膜有黑色絮状物。④卵泡液化、变性坏死、萎缩。
肉鸡方面:a病鸡气囊增厚,内有云雾状病变;肠系膜发黑。严重病例部分气囊、肠系膜出现明显霉菌结节。b肺脏变化,多成纤维素性肺炎或出血性肺炎。c肌胃溃烂,角质层四分五裂,部分有明显溃疡灶;腺胃肿大呈椭圆型或梭形,腺胃壁增厚,乳头出血、水肿。d肝脏肿大,部分脂肪变性,上有肿瘤硬化;大部分出现肝脏边沿变薄如刀刃,严重病例肝脏上有霉菌结节。脾脏和肾脏肿大、表面浆膜有大量灰白色坏死灶。

6.本病难以诊断
6.1难以诊断的原因
在临床病例中,病禽的一些症状时常被经验不足的兽医误指成其他病。
有些霉菌毒素对蛋鸡生产性能的抑制,在开始的短时间内体现不出来,随着时间推移体内毒素作用积累增多,到中期开始表现直至后期。曾有一例蛋鸡,在中毒后的发病前期,采食由细慢、叨料到逐渐减少,后发展为拒食而产蛋还在上升,至高峰维持25天后才开始下降。据分析,这是因为此批鸡育雏育成良好,又正处于产蛋上升期,生殖机能旺盛,而营养的负平衡是在25天后才显现出来,这种表面现象很容易误导诊断。
新生雏鸡1日龄即有明显呼吸道症状,仅10%有肺霉斑变化,这就容易误诊为支原体病,发病于4日龄后的雏鸡,往往生长不良、采食少、体重轻,会被认为是弱雏,霉菌毒素中毒还会使15日龄小公鸡出现打鸣,鸡冠发育过度,这主要是过量玉米赤霉烯酮引起,会被误认为发育早。
赭曲霉毒素中毒主要是肾损伤,表现为利尿作用加强,此时,鸡群多尿脱水,由于利尿水泄,蛋鸡拉稀久治不愈,产蛋下降,肉仔鸡生长缓慢,贫血,形成佝偻症。
6.2应如何辨别

以下几个霉菌毒素感染的原因就解答许多养殖户,甚至是许多从业人员的困惑。
烟曲霉菌致病后,病禽头颈伸直呈沙哑的水泡声呼吸、甩鼻、打喷嚏、眼部潮红肿胀、溃疡,眼鼻分泌物增多,下痢、扭颈、共济失调,成年禽呈慢性经过性发育不良、消瘦、贫血、停产、呆立、少食、羽毛粗乱,还有剖检中的脏器肉芽肿、腺胃肿胀等。
黄曲霉菌侵害的幼禽和成禽表现为少食、叨料、腹泻或稀便混血、双翅下垂、脱毛、消瘦、鸡冠苍白、产蛋下降、种蛋孵化率降低等。因此,强调鉴别诊断上要注意与雏鸡白痢、支原体、大肠杆菌病、雏鸡脑脊髓炎、雏鸡新城疫等的区别,确有必要。
白色念珠菌病又称霉菌性口腔炎,俗称鹅口疮。患病鸡、鸭、鹅表现为精神不振、少食、消瘦、羽毛脏乱、嗉囊胀满,挤压有痛感,下痢,雏鸭还会有急促喘气,叫声嘶哑等症,确诊此病特别要注意病禽口腔、食道,看是否有灰白色假膜和溃疡,多数还会有眼睑、口角出现痂皮,呈白色丘疹样,后蔓延成片。
7预防措施
7.1农作物方面的预防
1、 选用和培育抗菌的饲料作物品种
2、 选择适当的种植或收获技术
3、 严格控制饲料和原料的水分含量
4、 改善贮藏条件,抑制霉菌生长。物理防霉法、化学防霉法添加防霉剂、微生物抑制法。
7.2饲料生产方面对霉菌的预防
1 加强饲料生产的管理
2 合理使用饲料防霉剂
7.3养殖端的防治措施
A. 提高饲养管理水平,确保鸡舍良好的环境卫生和空气质量。

B. 选择新型的即可杀灭霉菌又可脱霉解毒的产品(化毒丹),并定期使用
C. 发生霉菌毒素中毒时,首先更换饲料,并配合化毒丹使用。高效脱霉解毒、保肝护肝、促进机体修复、防止继发感染同时激活机体免疫。乎必妥配合使用预防发生呼吸道,更好的提高肝脾的生理作用。
1